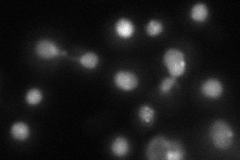
YOR191W
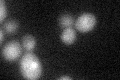
YOR191W

View description
RING finger protein involved in proteolytic control of sumoylated substrates; interacts with SUMO (Smt3p); member of the SWI/SNF family of DNA-dependent ATPases; plays a role in antagonizing silencing during mating-type switching
Localization:
Intensity:
Fold change:
Significance:
-
C’ GFP library in SD

nucleus18.01 -
N' NOP1pr-GFP in SD

punctate,nucleus61.2164 -
N' TEF2pr-mCherry in SD
punctate,nucleus36.4852 -
N' NATIVEpr-GFP in SD

nucleus21.4462 -
N' TEF2pr-VC and Cyto-VN in SD

below threshold24.857 -
C’ GFP library in SD+DTT
nucleus18.461.02No -
C’ GFP library in SD+H2O2

nucleus20.541.14No -
C’ GFP library in Starvation Media

nucleus16.850.93No -
C’ GFP library on the background of Pup2-DaMP

nucleus -
C’ GFP library on the background of CCT mutant

nucleus21.29361.18166No
